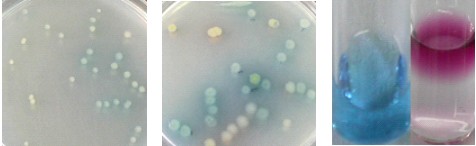
銅綠假單胞菌生長后菌落顏色形 態及綠膿菌素試驗顏色反應

綠膿菌素測定用對照培養基基礎分析證書( COA)
中文名稱:綠膿菌素測定用對照培養基基礎
英文名稱:Base of Pseudomonas Agar P Reference Medium(BPAPRM)
配方:參見 2010 版中國藥典。
外觀:本品為類白色均一粉末,加入水中混懸均勻,滅菌后融化狀態為清澈黃色透明液體。
裝量:本品標示裝量 13.9g/袋/300mL,平均裝量 13.97g/袋,RSD=0.14%(n=10,S=0.02g)。
酸度:本品滅菌后 pH 7.2,符合 2010 版中國藥典滅菌后 pH7.3±0.1 的規定。
生長能力&指示能力:取 2010 版中國藥典收載的銅綠假單胞菌 (Pseudomonasaeruginosa) [CMCC(B) 10104],以 50-100cfu 接種至該批培養基中,30-35℃培養 24 小時后,測試菌株均生長良好。銅綠假單胞菌生長后菌落顏色形態及綠膿菌素試驗顏色反應見下圖。
左圖:銅綠假單胞菌在該批綠膿菌素測定用對照培養基表面培養 24 小時的生長形態;
中圖:銅綠假單胞菌在該批綠膿菌素測定用對照培養基表面培養 48 小時的生長形態;
右圖:綠膿菌素提取(左試管)及顏色反應(右試管)。
該批對照培養基滿足 2010 年版《中國藥典》培養基適用性實驗的要求,可用于培養基適用性檢查對比實驗。
點擊查看→→產品價格

